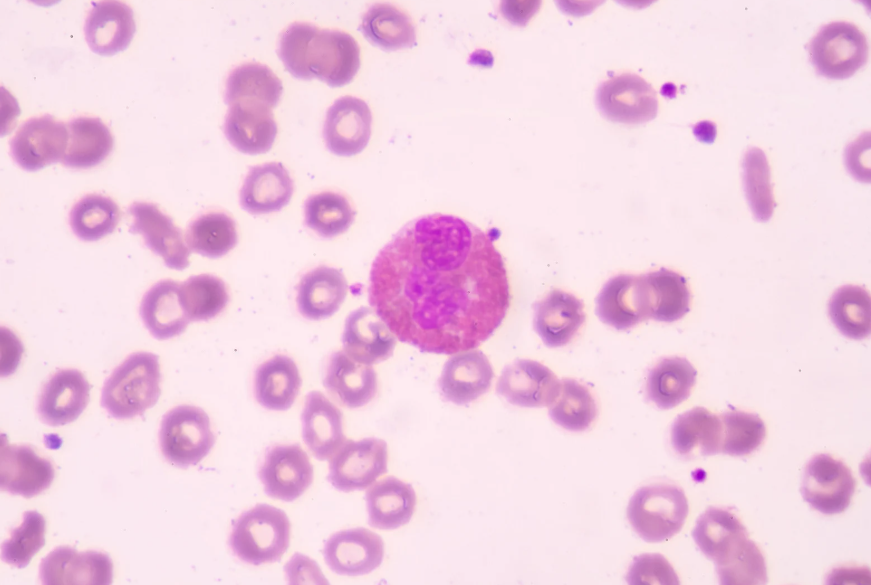
white blood cell among red blood cells illustrating what your immune system does all day

Your immune system’s job is not to eliminate everything foreign. It’s to distinguish between what’s harmless, what’s helpful, and what’s dangerous, and then respond appropriately.
You probably only think about your immune system when you feel sick. But long before symptoms appear, your immune system has been working continuously, monitoring, identifying, filtering, and repairing. Every breath, every meal, and every surface you touch introduces potential invaders. It doesn’t wait for a cold or infection to activate. It operates around the clock, quietly managing threats you never notice.
Constant Surveillance and Threat Detection
Your immune system functions like a highly coordinated security network. Physical barriers, such as your skin and the linings of your nose, lungs, and digestive tract, serve as the first line of defense. These barriers block many pathogens before they ever enter deeper tissues.
If something slips past those barriers, immune cells immediately begin surveillance. White blood cells patrol the bloodstream and tissues, searching for unusual signals. They recognize specific molecular patterns found on bacteria, viruses, and damaged cells.
Specialized cells called macrophages and dendritic cells act as both defenders and messengers. They engulf invaders and then display pieces of them on their surface, alerting other immune cells. This communication is how your immune system shifts from passive monitoring to active response.
Read What Happens During Digestion From Start to Finish for gut defense support.
Coordinating an Immediate Response
When a genuine threat is detected, the immune system launches an innate response. This is the fast-acting, non-specific defense system you’re born with. It includes inflammation, fever, and the release of signaling molecules called cytokines.
Inflammation is often misunderstood as harmful, but in the short term, it’s protective. Increased blood flow brings more immune cells to the affected area. Swelling helps isolate the threat. Heat and redness are signs that the immune system is actively working.
At the same time, natural killer cells and other immune components begin destroying infected or abnormal cells. This early response happens within minutes to hours and buys time for a more targeted strategy to develop.
See What Happens to Your Body During Stress for stress and immune signaling.
Building Targeted Memory
If a pathogen requires a more precise attack, the adaptive immune system steps in. This branch involves B cells and T cells, which recognize specific invaders. Unlike the innate response, this process takes several days to activate fully.
B cells produce antibodies, which are proteins that bind to specific viruses or bacteria, marking them for destruction. T cells either coordinate the response or directly destroy infected cells. This targeted approach allows the immune system to eliminate threats efficiently.
One of the most remarkable features of adaptive immunity is memory. After an infection resolves, memory cells remain. If the same pathogen appears again, the immune system can respond faster and more effectively. Vaccines train the immune system’s memory without causing severe illness.
Explore What Is Chronic Fatigue? for more on energy and immune strain.
Cleaning Up and Repairing
Once a threat has been neutralized, the immune system doesn’t simply switch off. It shifts into resolution mode. Inflammation subsides, damaged tissue is repaired, and excess immune cells are cleared away.
This phase is just as important as the attack phase. If inflammation continues unnecessarily, it can damage healthy tissues. That’s why regulation is critical. The immune system must know when to escalate and when to stand down.
Daily immune activity also includes removing old or malfunctioning cells. Your body constantly produces and recycles cells, and immune cells help clear debris to maintain healthy tissue function.
Learn What Is Metabolic Syndrome? for inflammation and metabolic health.
Balancing Defense Without Overreaction
A healthy immune system is balanced, neither overly aggressive nor underactive. When the immune response is too weak, infections can take hold more easily. When it’s too aggressive, it can lead to allergies or autoimmune conditions, where the body mistakenly attacks its own tissues.
Sleep, nutrition, stress levels, and overall health influence immune function. Chronic stress and poor sleep can disrupt immune regulation, making responses less efficient. Adequate rest and nutrient-dense foods help maintain proper signaling and cell production.
Your immune system doesn’t operate in isolation. It communicates with the nervous system, the endocrine system, and even the gut microbiome. This integration allows it to adapt continuously to internal and external conditions.
Understanding what your immune system is doing all day reveals something important: it’s not waiting for emergencies. It’s constantly scanning, adjusting, remembering, and repairing. When it works well, you rarely notice it. And that’s exactly the point.